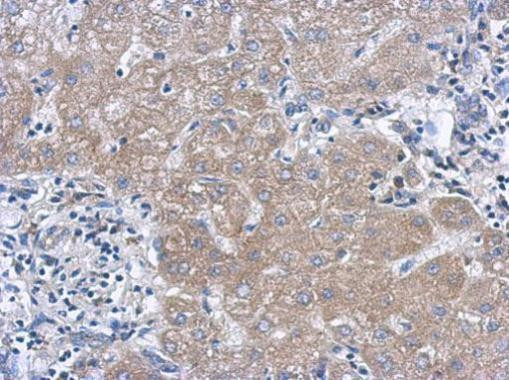
IL-27 p28 Antibody in Immunohistochemistry (Paraffin) (IHC (P))

Search
Invitrogen
IL-27 p28 Polyclonal Antibody
{{$productOrderCtrl.translations['antibody.pdp.commerceCard.promotion.promotions']}}
{{$productOrderCtrl.translations['antibody.pdp.commerceCard.promotion.viewpromo']}}
{{$productOrderCtrl.translations['antibody.pdp.commerceCard.promotion.promocode']}}: {{promo.promoCode}} {{promo.promoTitle}} {{promo.promoDescription}}. {{$productOrderCtrl.translations['antibody.pdp.commerceCard.promotion.learnmore']}}
产品信息
PA5-78661
种属反应
宿主/亚型
分类
类型
抗原
偶联物
形式
浓度
规格
纯化类型
保存液
内含物
保存条件
运输条件
RRID
产品详细信息
Positive Control: 3XFlag-human IL-27 -transfected 293T
Store product as a concentrated solution. Centrifuge briefly prior to opening the vial.
靶标信息
IL-27, a member of the IL-12 family, is a heterodimeric protein consisting of the p40-related protein Epstein-Barr virus-induced gene 3 (EBI3) non-covalently linked to an IL-12p35-related protein, p28 (also known as IL-30). IL-27 is produced by activated APCs and mature dendritic cells. IL-27 exerts its activities on NK cells and naive CD4+ T cells; mRNA expression analysis of IL-27 receptor components (WSX-1/TCCR and gp130) suggests that IL-27 may also target other cells, including mast cells and monocytes. Binding of IL-27 to WSX-1/gp130 activates JAK1, STAT1, and STAT3 and STAT1/3 phosphorylation. WSX-1/TCCR-deficient mice develop impaired Th1 responses and are more susceptible to infection with L. monocytogenes suggesting that Th1 responses require IL-27. Although activation of WSX-1 is required for the initiation of Th1 responses, it is not necessary for maintaining Th1 responses. IL-27 alone is not able to induce the differentiation of CD4+ T cells into IFN-γ-producing cells, suggesting a role for IL-27 as an initial activator of Th1 responses. An important effect of IL-27 in initiating Th1 responses is the induction of the Th1-specific transcription factor T-bet as well as the suppression of the Th2-specific transcription factor GATA-3. T-bet plays a critical role in Th1 differentiation by its ability to maintain IL-12Rβ2 expression following CD4+ T cell activation. Recent studies indicate that IL-27 has a potent antitumor activity. In vitro, IL-27 has been found to act directly on naive CD8 cells, generating CTL with enhanced granzyme B expression. In vivo, IL-27 has been reported to augment CTL activity, inhibit tumor growth, and induce complete regression of primary and metastatic neuroblastoma tumors.
⚠WARNING: This product can expose you to chemicals including mercury, which is known to the State of California to cause birth defects or other reproductive harm. For more information go to www.P65Warnings.ca.gov.
仅用于科研。不用于诊断过程。未经明确授权不得转售。
篇参考文献 (0)
生物信息学
蛋白别名: IL-27 p28 subunit; IL-27 subunit alpha; IL-27-A; IL-30; IL27-A; ILN; Interleukin; Interleukin-27; Interleukin-27 subunit alpha; Interleukin-30; p28
基因别名: IL-27; IL-27A; IL27; IL27A; IL27p28; IL30; p28
UniProt ID: (Human) Q8NEV9
Entrez Gene ID: (Human) 246778